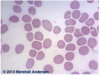
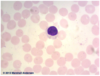
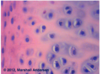
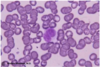
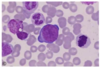
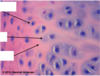
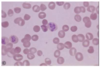
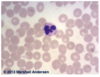
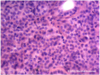

Histology - Tissue Identification Flashcards
(234 cards)
1
Q
Identify:

A

2
Q
Identify:

A

3
Q
Identify:

A

4
Q
Identify:

A

5
Q
Identify:

A

6
Q
Identify:

A

7
Q
Identify:

A
Trasitional Epithelium / Urothelium
8
Q
Identify:

A
Dense Bone
9
Q
Identify:

A
Cancellous Bone
10
Q
Identify:

A
Adipose Tissue
11
Q
Identify:

A
Purkinje Cell
12
Q
Identify:

A

13
Q
Identify:

A
Simple Cuboidal (Kidney)

14
Q
Identify:

A

15
Q
Identify:

A
Pseudostratified Columnar Epithelium

16
Q
Identify:

A
Transitional Epithelium

17
Q
Identify:

A
Mammary Gland (inactive)
- 1st pic shows cross section of duct.
- 2nd pic shows ducts and connective tissue.

18
Q
Identify:

A
Hyaline Cartilage
19
Q
Identify:

A
Skeletal Muscle
20
Q
Identify:

A

21
Q
Identify:

A
Cardiac Muscle
22
Q
Identify:

A

23
Q
Identify:

A
Smooth Muscle
24
Q
Identify:

A

25
Identify:

Cerebral Cortex - Pyramidal Cells
26
Identify:


27
Identify:

Stratified squamous epithelium - non-keratinized.
* See the presence of the nucleus in squamous cells.
28
Identify:


29
Identify:

Stratified squamous eithelium - Keratinized
* See lack of nucleus in squamous cells and flaking of cells at surface.
30
Identify:


31
Identify:

Simple cuboidal epithelium.
* Photomicrograph of kidney tubules
32
Identify:


33
Identify:

Stratified squamous - non keratinized
34
Identify:


35
Identify:

Simple cuboidal epithelium
36
Identify:

Submandibular Gland
* Both serous and mucous cells.
* Serous cells form serous demilune capping mucous acini.
* Myoepithelial cells surround acini.

37
Identify:

Simple columnar
38
Identify:

Submandibular Gland
* Both serous and mucous cells.
* Serous cells form serous demilune capping mucous acini.
* Myoepithelial cells surround acini.

39
Identify:

Transitional epithelium / Urothelium
40
Identify:

Submandibular Gland
* Both serous and mucous cells.
* Serous cells form serous demilune capping mucous acini.
* Myoepithelial cells surround acini.

41
Identify:

Simple columnar
42
Identify:

Sublingual Gland
* Mucous acini (pale in appearance)(PAS+)
* Flattened nuclei at basal poles of cells.
* Myoepithelial cells surround acini.
43
Identify:

Pseudostratified epithelium
44
Identify:

Submandibular Gland
* Both serous and mucous cells.
* Serous cells form serous demilune capping mucous acini.
* Myoepithelial cells surround acini.

45
Identify:


46
Identify:

Simple cuboidal
47
Identify:

Parotid Gland
* Serous acini
* Apical regions contain zymogen granules.
* RER predominates in basal regions of secretory cells.

48
Identify:


49
Identify:

Transitional epithelium / Urothelium
50
Identify:

Parotid Gland
* Serous acini
* Apical regions contain zymogen granules.
* RER predominates in basal regions of secretory cells.
51
Identify:


52
Identify:

Simple cuboidal
* Thyroid tissue showing thyroxine globules.
53
Identify:

Parotid Gland
* Serous acini
* Apical regions contain zymogen granules.
* RER predominates in basal regions of secretory cells.
54
Identify:


55
Identify:

Simple columnar
56
Identify:

Submandibular Gland
* Both serous and mucous cells.
* Serous cells form serous demilune capping mucous acini.
* Myoepithelial cells surround acini.
57
Identify:

Review lecture 11/13/18 for description.

58
Identify:

Sublingual Gland
* Mucous acini (pale in appearance)(PAS+)
* Flattened nuclei at basal poles of cells.
* Myoepithelial cells surround acini.

59
Identify:

Submandibular Gland
* Both serous and mucous cells.
* Serous cells form serous demilune capping mucous acini.
* Myoepithelial cells surround acini.

60
Identify:
Sickle Cell Erythrocytes
61
Identify:

Parotid Gland
* Serous acini
* Apical regions contain zymogen granules.
* RER predominates in basal regions of secretory cells.

62
Identify:

Submandibular Gland
* Both serous and mucous cells.
* Serous cells form serous demilune capping mucous acini.
* Myoepithelial cells surround acini.

63
Identify:

Neutrophils 1000x
64
Identify:

Submandibular Gland
* Both serous and mucous cells.
* Serous cells form serous demilune capping mucous acini.
* Myoepithelial cells surround acini.

65
Identify:

Submandibular Gland
* Both serous and mucous cells.
* Serous cells form serous demilune capping mucous acini.
* Myoepithelial cells surround acini.

66
Identify:
Eosinophil

67
Identify:

Parotid Gland
* Serous acini
* Apical regions contain zymogen granules.
* RER predominates in basal regions of secretory cells.

68
Identify:

Submandibular Gland
* Both serous and mucous cells.
* Serous cells form serous demilune capping mucous acini.
* Myoepithelial cells surround acini.
69
Identify:

Basophil
70
Identify:

Sublingual Gland
* Mucous acini (pale in appearance)(PAS+)
* Flattened nuclei at basal poles of cells.
* Myoepithelial cells surround acini.
71
Identify:


72
Identify:
Lymphocyte 1000x
73
Identify:

Sublingual Gland
* Mucous acini (pale in appearance)(PAS+)
* Flattened nuclei at basal poles of cells.
* Myoepithelial cells surround acini.
74
Identify:


75
Identify:

Monocyte 1000x
76
Identify:

Sublingual Gland
* Mucous acini (pale in appearance)(PAS+)
* Flattened nuclei at basal poles of cells.
* Myoepithelial cells surround acini.

77
Identify:
Hyaline Cartilage
78
Identify:

Promegakaryocyte
79
Identify:

Sublingual Gland
* Mucous acini (pale in appearance)(PAS+)
* Flattened nuclei at basal poles of cells.
* Myoepithelial cells surround acini.

80
Identify:

Elastic Cartilage
81
Identify:
Promegakaryocyte
82
Identify:

Sublingual Gland
* Mucous acini (pale in appearance)(PAS+)
* Flattened nuclei at basal poles of cells.
* Myoepithelial cells surround acini.
83
Identify:

Fibrous Cartilage
84
Identify:

Proerythroblast
85
Identify:

Submandibular Gland
* Both serous and mucous cells.
* Serous cells form serous demilune capping mucous acini.
* Myoepithelial cells surround acini.

86
Identify:


87
Identify:
Proerythroblast
88
Identify:

Submandibular Gland
* Both serous and mucous cells.
* Serous cells form serous demilune capping mucous acini.
* Myoepithelial cells surround acini.

89
Identify:

90
Identify:
Reticulocytes
91
Identify:


92
Identify:


93
Identify:

Skeletal Muscle
94
Identify:


95
Identify:


96
Identify:

Skeletal Muscle
97
Identify:


98
Identify:


99
Identify:

Skeletal Muscle
100
Identify:


101
Identify:


102
Identify:

Skeletal Muscle
103
Identify:


104
Identify:

Developing membrane bone in fetus.
105
Identify:

Skeletal Muscle
106
Identify:


107
Identify:

NAD stain (oxidative phosphorylation) - Type I fibers stain darker than type II fibers.

108
Identify:


109
Identify:

Smooth Muscle
110
Identify:


111
Identify:

Cardiac Muscle
112
Identify:


113
Identify:

Cardiac Muscle - Acute MI
114
Identify:


115
Identify:

Satellite Cells

116
Identify:


117
Identify:

Muscle Spindles

118
Identify:


119
Identify:

Cardiac Muscle
120
Identify:


121
Identify:

Cardiac Muscle
122
Identify:


123
Identify:

Cardiac Muscle - AMI
124
Identify:


125
Identify:

Cardiac Muscle - Purkinje Fibers
126
Identify:


127
Identify:

Smooth Muscle
128
Identify:


129
Identify:

Smooth Muscle
130
Identify:


131
Identify:


132
Identify:


133
Identify:


134
Identify:
Normal RBCs
135
Identify:


136
Identify:


137
Identify:


138
Identify:


139
Identify:


140
Identify:


141
Identify:

Astrocytes around capillary
142
Identify:

Astrocyte
143
Identify:


144
Identify:

Pseudounipolar Neuron in Dorsal Root Ganglion
145
Identify:


146
Identify:


147
Identify:


148
Identify:


149
Identify:


150
Identify:


151
Identify:


152
Identify:


153
Identify:


154
Identify:


155
Identify:


156
Identify:


157
Identify:


158
Identify:


159
Identify:


160
Identify:

Lymph Node

161
Identify:

Atherosclerosis of Aorta
* M = tunica media
* I = tunica intima with large atheromatous lesion.

162
Identify:


163
Identify:

Submandibular Gland
* Both serous and mucous cells.
* Serous cells form serous demilune capping mucous acini.
* Myoepithelial cells surround acini.

164
Identify:


165
Identify:

Sublingual Gland
* Mucous acini (pale in appearance)(PAS+)
* Flattened nuclei at basal poles of cells.
* Myoepithelial cells surround acini.
166
Identify:


167
Identify:

Submandibular Gland
* Both serous and mucous cells.
* Serous cells form serous demilune capping mucous acini.
* Myoepithelial cells surround acini.

168
Identify:


169
Identify:

Parotid Gland
* Serous acini
* Apical regions contain zymogen granules.
* RER predominates in basal regions of secretory cells.

170
Identify:


171
Identify:

Parotid Gland
* Serous acini
* Apical regions contain zymogen granules.
* RER predominates in basal regions of secretory cells.
172
Identify:


173
Identify:

Parotid Gland
* Serous acini
* Apical regions contain zymogen granules.
* RER predominates in basal regions of secretory cells.
174
Identify:


175
Identify:

Submandibular Gland
* Both serous and mucous cells.
* Serous cells form serous demilune capping mucous acini.
* Myoepithelial cells surround acini.
176
Identify:


177
Identify:

Submandibular Gland
* Both serous and mucous cells.
* Serous cells form serous demilune capping mucous acini.
* Myoepithelial cells surround acini.

178
Identify:


179
Identify:

Submandibular Gland
* Both serous and mucous cells.
* Serous cells form serous demilune capping mucous acini.
* Myoepithelial cells surround acini.

180
Identify:


181
Identify:

Submandibular Gland
* Both serous and mucous cells.
* Serous cells form serous demilune capping mucous acini.
* Myoepithelial cells surround acini.

182
Identify:


183
Identify:

Submandibular Gland
* Both serous and mucous cells.
* Serous cells form serous demilune capping mucous acini.
* Myoepithelial cells surround acini.
184
Identify:


185
Identify:

Sublingual Gland
* Mucous acini (pale in appearance)(PAS+)
* Flattened nuclei at basal poles of cells.
* Myoepithelial cells surround acini.

186
Identify:


187
Identify:
Parotid Gland
* Serous acini
* Apical regions contain zymogen granules.
* RER predominates in basal regions of secretory cells.

188
Identify:

Simple Cuboidal Epithelium
189
Identify:

Submandibular Gland
* Both serous and mucous cells.
* Serous cells form serous demilune capping mucous acini.
* Myoepithelial cells surround acini.

190
Identify:

Simple Cuboidal Epithelium
191
Identify:

Parotid Gland
* Serous acini
* Apical regions contain zymogen granules.
* RER predominates in basal regions of secretory cells.

192
Identify:

Stratified Squamous Epithelium - Skin
193
Identify:

Sublingual Gland
* Mucous acini (pale in appearance)(PAS+)
* Flattened nuclei at basal poles of cells.
* Myoepithelial cells surround acini.
194
Identify:

Cerebral Cortez - Pyramidal Cells

195
Identify:

Sublingual Gland
* Mucous acini (pale in appearance)(PAS+)
* Flattened nuclei at basal poles of cells.
* Myoepithelial cells surround acini.
196
Identify:

Purkinje Cell in Cerebral Cortex
197
Identify:

Sublingual Gland
* Mucous acini (pale in appearance)(PAS+)
* Flattened nuclei at basal poles of cells.
* Myoepithelial cells surround acini.

198
Identify:

Eye Development in 72 Hr Chick Embryo

199
Identify:

Sublingual Gland
* Mucous acini (pale in appearance)(PAS+)
* Flattened nuclei at basal poles of cells.
* Myoepithelial cells surround acini.

200
Identify:


201
Identify:

Sublingual Gland
* Mucous acini (pale in appearance)(PAS+)
* Flattened nuclei at basal poles of cells.
* Myoepithelial cells surround acini.
202
Identify:

Anatomy of Eye

203
Identify:


204
Identify:

Tunics of Eye

205
Identify:


206
Identify:

Cornea

207
Identify:


208
Identify:


209
Identify:


210
Identify:


211
Identify:


212
Identify:


213
Identify:


214
Identify:


215
Identify:


216
Identify:


217
Identify:


218
Identify:


219
Identify:


220
Identify:


221
Identify:


222
Identify:


223
Identify:


224
Identify:


225
Identify:


226
Identify:


227
Identify:


228
Identify:


229
Identify:


230
Identify:


231
Identify:


232
Identify:


233
Identify:


234
Identify:




